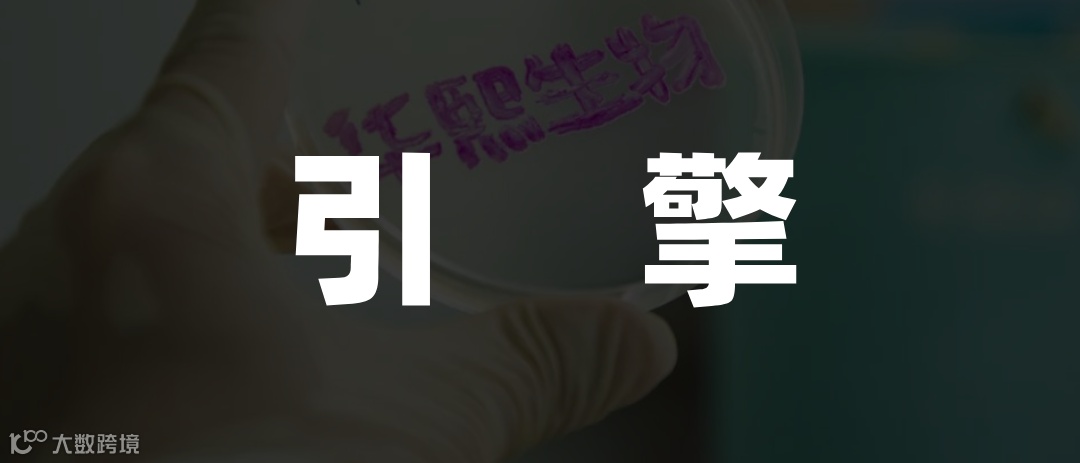

华熙生物深水区挑战:寻找新增长引擎


上市公司半年报披露后,美妆行业上半年的表现仍备受关注。华熙生物作为“玻尿酸第一股”,在发展高峰后的阵痛期中股价回落至46元上下,市值蒸发超1200亿元。
尽管曾是市场宠儿,但华熙生物的辉煌背后或许早已埋下了问题的种子。近年来,国货美妆品牌崛起,国际大牌美妆在国内市场份额逐渐下滑。雅诗兰黛、宝洁、欧莱雅等国际品牌在中国大陆市场的表现均不尽如人意。
01 华熙生物业绩拉垮

据统计,12家国货美妆上市公司上半年总营收达290.24亿元,同比增长13.17%。珀莱雅、贝泰妮等公司表现亮眼,而华熙生物的业绩却出现下滑。
财报显示,华熙生物上半年实现营收28.1亿元,同比下降8.61%;净利润3.42亿元,同比下降19.51%。功能性护肤品业务收入为13.81亿元,同比下滑29.74%。
对此,华熙生物表示,主要因管理变革产生短期费用影响了经营成果。
02 第二增长曲线难寻

作为全球最大的玻尿酸生产商,华熙生物曾凭借技术优势引领行业。然而,随着市场竞争加剧,其价格壁垒被逐步打破。
一方面,玻尿酸市场竞争激烈,国内外品牌相继推出低价产品。另一方面,其他活性成分如A醇、烟酰胺等逐渐占据市场,玻尿酸不再是唯一选择。
近年来,华熙生物尝试布局肉毒素和胶原蛋白赛道,但未见显著成效。与Medytox的合作终止,胶原蛋白业务也未能形成新的增长点。
03 医美能成新引擎吗?
虽然功能性护肤品业务承压,但华熙生物的医美业务呈现强劲增长态势。上半年医疗终端业务收入达7.43亿元,同比增长51.92%。
中国医美市场规模不断扩大,轻医美成为细分领域热点。润致娃娃针等产品表现优异,但医美业务占比仍较小,未来发展前景尚需观察。
此外,华熙生物内部管理问题频发,核心技术人员流失等也为未来发展带来不确定性。
综上所述,华熙生物正处于改革阵痛期,需肃清内部管理并开拓医美市场,同时继续探索新的增长引擎。


